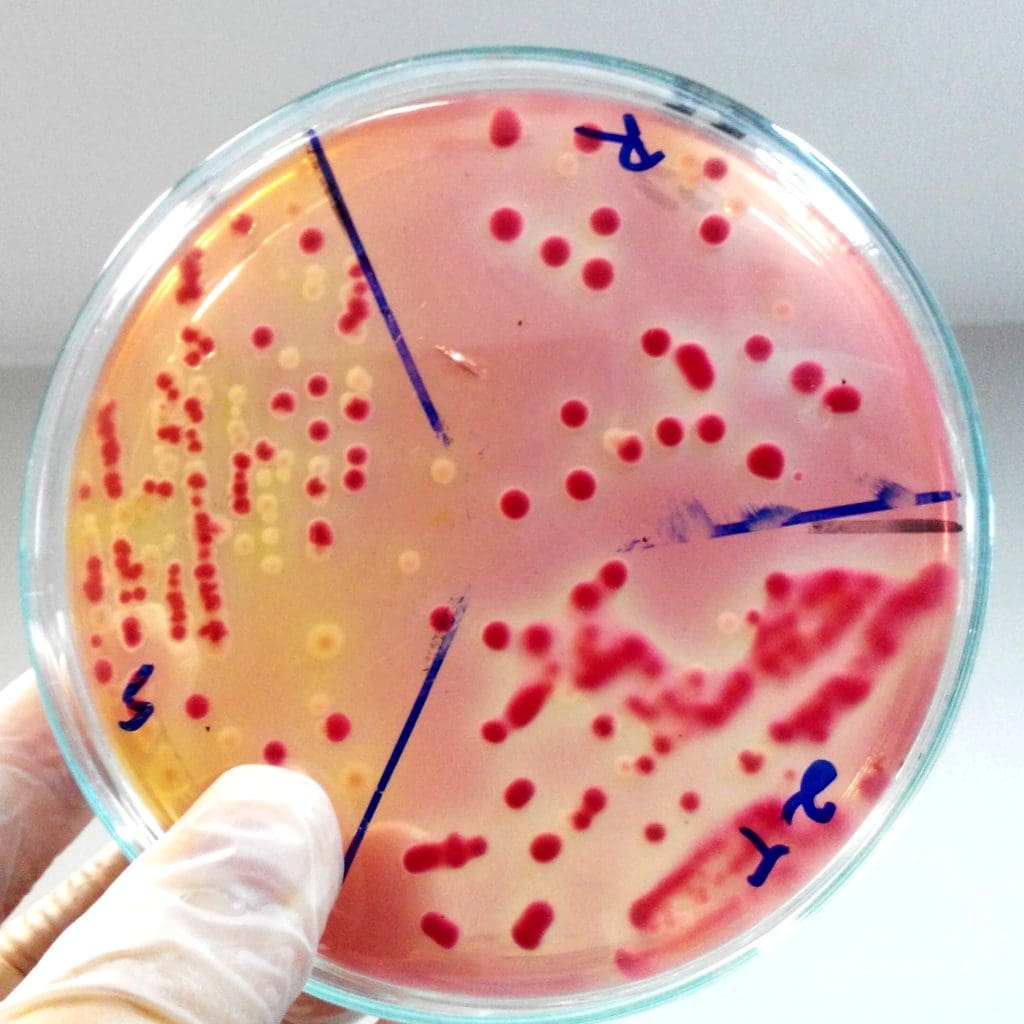
What Food is Good for MDS? A Patient Nutrition Guide 1 cropped hand scientist holding agar plate with blood laboratory LIV Hospital

Myelodysplastic syndrome (MDS) is a group of disorders. They are caused by poorly formed or dysfunctional blood cells. This often leads to anemia, infection, and bleeding. Nutrition plays a key role in managing MDS. A well-balanced diet can help ease symptoms and improve life quality.
A personalized nutrition guide helps MDS patients make better food choices. This can potentially improve their mds disease prognosis. This article will look at the best foods for MDS patients. It will also explain how diet affects the condition.
Key Takeaways
- Understanding the role of nutrition in managing MDS.
- Identifying beneficial foods for MDS patients.
- Learning how diet can impact MDS symptoms.
- Discovering how to create a personalized nutrition plan.
- Understanding the importance of a balanced diet in improving quality of life.
Understanding Myelodysplastic Syndrome (MDS) and Nutrition
Myelodysplastic syndrome (MDS) is a group of disorders caused by poorly formed or dysfunctional blood cells. This often leads to bone marrow failure. It can greatly affect a person’s quality of life, making it key to understanding its impact.
What is MDS and How it Affects the Body
MDS is marked by the production of defective blood cells. This can cause health issues like anemia, infections, and bleeding disorders. The bone marrow’s failure to produce healthy cells can lead to fatigue, weakness, and a higher risk of infections.
The Connection Between Diet and Blood Health
Nutrition is vital in managing MDS. A balanced diet can help support blood health and lessen MDS symptoms. Foods rich in essential nutrients can help produce healthy blood cells.
| Nutrient | Role in Blood Health | Food Sources |
| Iron | Crucial for healthy red blood cells | Red meat, spinach, fortified cereals |
| Vitamin B12 | essential for the production of red and sanitary cells> | Animal products, fortified plant-based milk |
| Folate | N Page for DNA Page and repair | Leafy greens, legumes, fortified cereals |
The Role of Nutrition in MDS Disease Prognosis
MDS patients can greatly benefit from a good nutrition plan. This plan supports their treatment and overall health. Nutrition is key in managing Myelodysplastic Syndrome, affecting both the disease’s outcome and the patient’s life quality.
A balanced diet is essential for the body during MDS treatment. A famous hematologist said, “Nutrition is a cornerstone in managing MDS. It directly affects the patient’s ability to handle treatment and recover.”
How Diet Influences Blood Cell Production

Diet greatly affects blood cell production, which is vital for MDS patients. Eating foods rich in essential nutrients can help make healthy blood cells.
Key nutrients for blood cell production include iron, vitamin B12, and folate. It’s important to get enough of these nutrients to keep blood cells healthy.
Nutritional Support During MDS Treatment
Nutritional support is key during MDS treatment. It helps manage side effects and keeps the patient strong. A diet tailored to the individual’s needs can greatly improve treatment results.
A cancer nutrition specialist said, “A well-nourished patient can better handle MDS treatment. This leads to better outcomes and a higher quality of life.”
During treatment, focus on nutrient-dense foods. These include fruits, vegetables, whole grains, lean proteins, and healthy fats. This diet provides the necessary vitamins, minerals, and proteins.
Essential Nutrients for MDS Patients

For those with MDS, knowing about nutrition is key. A diet full of important nutrients can help control symptoms and boost health.
Iron: Finding the Right Balance
Iron is vital for MDS patients because it helps make healthy red blood cells. But, it’s important to get the right amount. Monitoring iron levels is key to avoid issues.
Eating foods high in iron like red meat, poultry, fish, beans, and fortified cereals is good. Also, foods with vitamin C help your body absorb iron better.
Vitamin B Complex and Folate
The Vitamin B complex, including folate, is important for making blood cells. Folate helps prevent anemia, a common problem for MDS patients. Foods like leafy greens, legumes, and fortified cereals are full of folate.
It’s also important to get enough Vitamin B12, mainly found in animal products. MDS patients might need supplements if they don’t get enough from their diet.
Antioxidants and Their Importance
Antioxidants protect cells from damage by free radicals, which can make MDS worse. Foods like fruits, vegetables, nuts, and seeds are full of antioxidants.
Eating foods rich in antioxidants can help fight oxidative stress. This might improve MDS patients’ outcomes.
Adding these nutrients to their diet can help MDS patients manage their condition better. It can also improve their quality of life.
Foods That Boost White Blood Cell Production
Certain foods can help make more white blood cells. This is key for managing MDS. Eating foods full of important nutrients can boost your immune system and fight off infections.
Zinc and Selenium-Rich Foods
Zinc and selenium are important for a strong immune system. Zinc-rich foods include oysters, beef, chicken, and cereals with added zinc. These foods help make more white blood cells. Selenium-rich foods like Brazil nuts, fish, and turkey also keep your immune system healthy.
Eating foods rich in these minerals can boost your immune system. For instance, oysters are not just full of zinc but also protein. Brazil nuts are packed with selenium and are easy to add to your snacks.
Vitamin C and E Sources
Vitamin C is great for boosting your immune system. Foods like oranges, grapefruits, strawberries, and bell peppers are full of vitamin C. They help make more white blood cells and keep your immune system strong.
Vitamin E is another antioxidant that’s important for your immune system. Nuts and seeds like almonds and sunflower seeds are full of vitamin E. Adding these to your diet can help fight off infections and keep you healthy.
Eating a balanced diet with zinc, selenium, vitamin C, and vitamin E can help people with MDS. It can boost their white blood cell production and improve their health.
Protein-Rich Foods for MDS Management
Protein is key for those with MDS, helping with health and managing the condition. It’s important for keeping muscles strong, boosting the immune system, and overall well-being.
A study shows, “A balanced diet with enough protein helps MDS patients stay strong and supports their treatment.” This is vital as MDS patients often feel tired and weak.
Animal Protein Sources

Animal-based proteins are packed with amino acids the body needs for repair and upkeep. These include:
- Lean meats like chicken, turkey, and lean beef
- Fish and seafood, which are also rich in omega-3 fatty acids
- Eggs, a versatile and protein-rich food
- Dairy products, including milk, cheese, and yogurt
Lean meats and fish are not only high in protein but also provide essential nutrients like iron and zinc.
“Incorporating lean protein into the diet can help MDS patients manage their condition more effectively.”
– Expert in Nutrition
Plant-Based Protein Options
For those who prefer or need a plant-based diet, there are many high-protein foods:
- Legumes, including beans, lentils, and peas
- Nuts and seeds, such as almonds, chia seeds, and hemp seeds
- Whole grains like quinoa and farro
- Soy products, including tofu, tempeh, and edamame
Plant-based proteins offer extra benefits like fiber and antioxidants, supporting overall health.
A nutritional expert says, “A balanced diet with a variety of protein sources can greatly support MDS patients’ health.”
Fruits and Vegetables Beneficial for MDS Patients
For those with Myelodysplastic Systema (MDS), the right foods are key. A diet full of fruits and vegetables is essential. They offer nutrients and antioxidants that boost health and may help with MDS.
Antioxidant-Rich Produce
Antioxidants fight oxidative stress, a big problem in MDS. Eating a variety of fruits and vegetables high in antioxidants is important. Here are some top choices:
- Berries like blueberries, strawberries, and raspberries are packed with vitamins C and E.
- Leafy greens such as spinach and kale are full of antioxidants and folate.
- Cruciferous vegetables like broccoli and cauliflower have sulforaphane.
Chong
These foods do more than just fight oxidative stress. They also bring other nutrients that are good for MDS patients.
Best Preparation Methods to Preserve Nutrients
How you prepare fruits and vegetables matters a lot. To get the most from them, try these methods:
- Steaming: It keeps the nutrients in vegetables, like vitamin C and B vitamins.
- Roasting: It makes veggies taste great without losing their nutrients, using little oil.
- Raw consumption: Eating them raw keeps nutrients in, but make sure to wash them well.
Choosing the right ways to prepare food helps MDS patients get the most from their diet.
Whole Grains and Fiber: Supporting Digestive Health During MDS
Whole grains and fiber are key for good digestive health in MDS patients. Myelodysplastic Syndrome (MDS) can cause digestive problems. Eating foods rich in whole grains and fiber can help.
Best Grain Options for MDS Patients
Whole grains offer fiber, vitamins, and minerals. For MDS patients, eating different whole grains is good. Here are some top grain choices:
- Oats: High in soluble fiber, oats can help lower cholesterol and improve digestion.
- Quinoa: A complete protein and rich in fiber, quinoa is great for health.
- Brown Rice: Full of fiber and manganese, brown rice aids digestion and gives essential minerals.
- Whole Wheat: Rich in fiber and nutrients, whole wheat products like bread and pasta are good for you.
Balancing Fiber Intake with Digestive Sensitivities
Fiber is important for digestion, but MDS patients might need to adjust their intake. Start with small amounts and watch how your body reacts. This helps avoid any bad effects.
| Fiber-Rich Foods | Benefits | Considerations for MDS Patients |
| Legumes (beans, lentils) | High in fiber and protein | May cause gas; introduce gradually |
| Fruits (apples, berries) | Rich in fiber and antioxidants | Choose fresh or frozen; avoid high sugar content |
| Vegetables (broccoli, carrots) | High in fiber and vitamins | Steam or cook to ease digestion |
Knowing the value of whole grains and fiber helps MDS patients make better food choices. This supports their digestive health and overall well-being.
Healthy Fats and Oils for Inflammation Management
For those with Myelodysplastic Syndrome, adding certain nutrients to their diet can help fight inflammation. Healthy fats and oils are key, helping to improve overall health and ease MDS symptoms.
Omega-3 fatty acids are a big part of an anti-inflammatory diet. These fats are known for their ability to reduce inflammation and are essential for the body.
Omega-3 Rich Foods
Some foods are packed with omega-3 fatty acids. Fatty fish like salmon and sardines are great sources. For those who don’t eat fish, flaxseeds and chia seeds are good alternatives.
It’s important to remember that while alcohol can be part of a diet, moderation is key. This is even more true for MDS patients, where alcohol’s impact can vary.
| Omega-3 Rich Foods | Nutritional Benefits |
| Salmon | High in EPA and DHA, supporting heart health and reducing inflammation |
| Sardines | Rich in omega-3s and calcium, supporting bone health |
| Flaxseeds | High in ALA, supporting heart health and potentially reducing inflammation |
Anti-inflammatory Oils and Their Uses
Certain oils are also known for their anti-inflammatory effects. Olive oil, rich in oleocanthal, is a common choice. Coconut oil and anti-inflammatory oils like flaxseed oil also have health benefits.
For MDS patients, using these oils in cooking or as dressings is simple. It’s important to balance their intake with other dietary needs. Choosing the right oils can subtly help manage MDS symptoms.
Foods to Limit or Avoid with MDS
People with MDS need to know which foods to limit or avoid. A diet made for MDS patients can help manage symptoms and improve health.
Processed Foods and Added Sugars
Processed foods and added sugars are bad for health, worse for MDS patients. They often lack nutrients and can cause weight gain and inflammation.
Avoid or limit: Packaged snacks, sugary drinks, and processed meats. Choose whole foods like fruits, veggies, whole grains, lean proteins, and healthy fats instead.
Iron-Rich Foods When Iron Overload is a Concern
Iron is key, but MDS patients with iron overload should watch their iron intake. This is because frequent blood transfusions can lead to too much iron.
- Red meat
- Iron-fortified cereals
- Certain types of beans and lentils
It’s important for these patients to work with their healthcare provider. They need to manage iron levels and adjust their diet.
Foods That May Interact with MDS Medications
MDS patients on medication should know about food-drug interactions. Some foods can change how the body absorbs or breaks down MDS meds, affecting their work or causing side effects.
Grapefruit and its juice can interact with many meds. Patients should talk to their healthcare provider or a dietitian to find out which foods to avoid while on treatment.
By paying attention to these dietary tips, MDS patients can manage their condition better. This can improve their quality of life.
MDS and Alcohol: What Research Shows
It’s important for MDS patients to know how alcohol affects their health. Studies show that alcohol can make managing MDS harder.
Alcohol’s Effect on Blood Cell Production
Alcohol consumption can harm blood cell production, which is key for MDS patients. Research finds that alcohol can make anemia, neutropenia, and thrombocytopenia worse in MDS.
Alcohol’s impact on blood cell production is complex. It can directly harm the bone marrow and change how nutrients are used for blood cell creation.
Recommendations for Alcohol Consumption with MDS
For MDS patients, moderation is key when it comes to alcohol. Some might need to avoid alcohol altogether, while others might be able to have a little.
- Consult healthcare providers for personalized advice on alcohol consumption.
- Be aware of the possible interactions between alcohol and MDS medications.
- Watch for health changes closely when drinking alcohol.
Understanding alcohol’s effects on MDS and following specific guidelines can help patients make better choices. This might improve their quality of life.
era>
Nutrition Strategies for Managing MDS Symptoms
Living with MDS means finding ways to ease symptoms. A good diet is key. It helps keep you healthy and manage your condition.
Dietary Approaches for Fatigue and Weakness
Fatigue and weakness are big challenges for MDS patients. Increasing protein intake can help. Foods like lean meats, fish, eggs, and legumes are great for muscle strength.
Adequate hydration is also important. Dehydration makes fatigue worse. Drinking lots of water is a must.
“A balanced diet that includes a variety of whole foods can help alleviate fatigue and support overall health in MDS patients.”
Nutritional Support During Infections and Low Immunity
MDS patients often get sick easily because of low immunity. Nutritional support is key during these times. Foods high in vitamin C, like citrus fruits and leafy greens, boost the immune system.
- Foods rich in antioxidants, like berries, help fight oxidative stress.
- Zinc in foods like oysters, beef, and chicken is good for the immune system.
- Omega-3 fatty acids in fish and flaxseeds reduce inflammation.
By following these nutrition tips, MDS patients can manage their symptoms better. This improves their quality of life quality.
Special Dietary Considerations for Elderly MDS Patients
Elderly MDS patients face special nutritional challenges. As they age, their dietary needs change. MDS adds to these challenges.
The elderly often have less appetite and digestion issues. They also have more health problems and take more medicines. This makes their diet very important.
Addressing Age-Related Nutritional Challenges
Elderly MDS patients need a diet that meets their nutritional needs. They should get enough protein to keep their muscles strong.
- Increasing protein intake through foods like lean meats, fish, and dairy products.
- Ensuring adequate hydration to prevent dehydration, a common issue in the elderly.
- Consuming a variety of fruits and vegetables to meet vitamin and mineral needs.
Adapting Diet for Treatment of MDS in Elderly
Treating MDS in the elderly often involves medicine and supportive care. Diet plays a big role in managing side effects and keeping them healthy.
For example, those getting chemotherapy may need more nutrition to fight nausea and mouth sores. Eating foods high in antioxidants and fiber can help.
| Nutritional Component | Benefit for Elderly MDS Patients | Food Sources |
| Protein | Maintains muscle mass and overall health | Lean meats, fish, eggs, dairy |
| Antioxidants | Reduces oxidative stress and inflammation | Fruits, vegetables, nuts, seeds |
| Fiber | Supports digestive health | Whole grains, fruits, vegetables |
In conclusion, elderly MDS patients have special dietary needs. Understanding and adapting to these needs helps improve their health and quality of life.
Conclusion: Integrating Dietary Changes into Your MDS Care Plan
Adding dietary changes is key to managing Myelodysplastic Syndrome (MDS). A good nutrition guide can really help. It supports blood cell making and overall health.
Patients should eat foods full of iron, vitamin B complex, and antioxidants. Foods with zinc, selenium, and omega-3 fatty acids help too. They boost white blood cells and cut down inflammation.
It’s important to work with doctors to make a nutrition plan that fits you. This plan should look at your age, treatment, and nutritional needs.
Choosing the right foods and adding them to your MDS care plan can improve your life. A balanced diet, along with medical care, is a strong way to manage MDS and keep you healthy for a long time.
FAQ
What is Myelodysplastic Page (MDS) and how does it Page affect the body?
Myelodysplastic Syndrome (MDS) is a group of disorders. It happens when blood cells are poorly formed or don’t work right. This leads to bone marrow failure. It makes it hard for the body to make healthy blood cells, causing health problems.
How does diet influence MDS management?
Diet is key in managing MDS. It helps make blood cells, keeps health up, and lessens symptoms. Eating well can make life better for MDS patients.
What are the essential nutrients for MDS patients?
MDS patients need iron, vitamin B complex, folate, and antioxidants. These nutrients help keep blood cells healthy and support overall health.
Can certain foods boost white blood cell production?
Yes, foods high in zinc, selenium, vitamins C and E can boost white blood cells. Oysters, beef, chicken, pumpkin seeds, sunflower seeds, citrus fruits, and nuts are good examples.
How does alcohol consumption affect MDS?
Drinking alcohol can harm MDS by affecting blood cell making and possibly mixing with MDS medicines. It’s best to drink less or not at all.
Are there specific dietary recommendations for elderly MDS patients?
Elderly MDS patients need special diets because of age-related nutrition issues. It’s important to adjust their diet to help their health during MDS treatment.
What foods should MDS patients limit or avoid?
MDS patients should eat less of processed foods, added sugars, and foods that might not work well with their medicines. They should also watch out for too much iron if they have iron overload.
Q: Can myelodysplastic syndrome be cured through dietary changes alone?
While diet changes can help manage MDS, they can’t cure it by themselves. A full treatment plan that includes medical care and nutrition is usually needed.
How can nutrition strategies help manage MDS symptoms?
Nutrition strategies can help with MDS symptoms like fatigue and weakness by giving essential nutrients and supporting health. They can also help during infections and when immunity is low.
What is the role of whole grains and fiber in supporting digestive health during MDS?
Whole grains and fiber are key for digestive health in MDS. They help with regular bowel movements and a healthy gut. It’s important to find the right balance to avoid digestive problems.
How do healthy fats and oils contribute to inflammation management in MDS?
Healthy fats and oils, like those with omega-3 fatty acids and anti-inflammatory compounds, help manage inflammation in MDS. They support health and may lessen symptom severity.